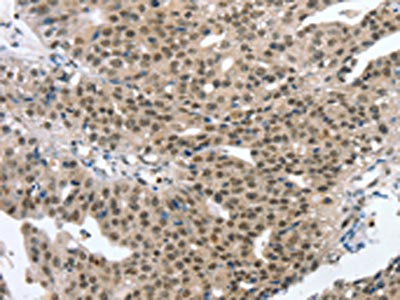

MED12 Antibody
-
中文名稱:MED12兔多克隆抗體
-
貨號(hào):CSB-PA833160
-
規(guī)格:¥1100
-
圖片:
-
其他:
產(chǎn)品詳情
-
Uniprot No.:
-
基因名:
-
別名:Activator recruited cofactor 240 kDa component antibody; Activator-recruited cofactor 240 kDa component antibody; ARC240 antibody; CAG repeat protein 45 antibody; CAGH45 antibody; HOPA antibody; KIAA0192 antibody; MED12 antibody; MED12_HUMAN antibody; Mediator complex subunit 12 antibody; Mediator of RNA polymerase II transcription subunit 12 antibody; OPA containing protein antibody; OPA-containing protein antibody; Thyroid hormone receptor associated protein complex 230 kDa component antibody; Thyroid hormone receptor-associated protein complex 230 kDa component antibody; TNRC11 antibody; Trap230 antibody; Trinucleotide repeat containing gene 11 protein antibody; Trinucleotide repeat-containing gene 11 protein antibody
-
宿主:Rabbit
-
反應(yīng)種屬:Human,Mouse
-
免疫原:Synthetic peptide of Human MED12
-
免疫原種屬:Homo sapiens (Human)
-
標(biāo)記方式:Non-conjugated
-
抗體亞型:IgG
-
純化方式:Antigen affinity purification
-
濃度:It differs from different batches. Please contact us to confirm it.
-
保存緩沖液:-20°C, pH7.4 PBS, 0.05% NaN3, 40% Glycerol
-
產(chǎn)品提供形式:Liquid
-
應(yīng)用范圍:ELISA,IHC
-
推薦稀釋比:
Application Recommended Dilution ELISA 1:2000-1:5000 IHC 1:25-1:100 -
Protocols:
-
儲(chǔ)存條件:Upon receipt, store at -20°C or -80°C. Avoid repeated freeze.
-
貨期:Basically, we can dispatch the products out in 1-3 working days after receiving your orders. Delivery time maybe differs from different purchasing way or location, please kindly consult your local distributors for specific delivery time.
-
用途:For Research Use Only. Not for use in diagnostic or therapeutic procedures.
相關(guān)產(chǎn)品
靶點(diǎn)詳情
-
功能:Component of the Mediator complex, a coactivator involved in the regulated transcription of nearly all RNA polymerase II-dependent genes. Mediator functions as a bridge to convey information from gene-specific regulatory proteins to the basal RNA polymerase II transcription machinery. Mediator is recruited to promoters by direct interactions with regulatory proteins and serves as a scaffold for the assembly of a functional preinitiation complex with RNA polymerase II and the general transcription factors. This subunit may specifically regulate transcription of targets of the Wnt signaling pathway and SHH signaling pathway.
-
基因功能參考文獻(xiàn):
- we aimed in this study to examine these common functional pathways in uterine leiomyomas (ULM)with different driver mutations. We collected ULM with MED12, HMGA2, and FH mutations and examined the selected markers by immunohistochemistry. PMID: 29790226
- Here, we observed that overexpression of HMGA2 mRNA in tumors measured by quantitative PCR and compared to myometrium is a common phenomenon in fibroids and is frequently associated with MED12 mutations. In addition, the common clonal origin of tumors overexpressing HMGA2 mRNA and its expression in few myometrial tissue points to HMGA2 up-regulation as an early event in leiomyoma tumorigenesis. PMID: 30017537
- Study confirmed the association of MED12 mutations with smaller leiomyoma size, multiplicity and conventional hystotype, and revealed novel associations between the MED12-mutation status and leiomyoma location and parity. PMID: 28432313
- High frequency of the MED12 mutation in uterine leiomyomas of South Korean patients. PMID: 29333096
- The high rate of TERT promoter mutations, MED12 mutations, RBM10 mutations, and chromosome 1q gain highlight their likely association with tumor virulence PMID: 28634282
- Role of MED12 as a tumor suppressor in other cancers to include CRC, and suggest TGF-beta signaling as a potential mediator of this effect. PMID: 28183795
- Hormonal status changing at various phases of menstrual cycle is a factor affecting DNA hydroxymethylation in leiomyoma cells. PMID: 28944423
- High MED12 expression is associated with small cell lung cancer. PMID: 28055980
- Data indicate that mediator complex subunit 12 (MED12) plays a central oncogenic role in breast fibroepithelial tumorigenesis. PMID: 27806318
- MED12 mutation does not appear to represent a significant molecular alteration in this cohort of patients according to the analysis by the traditional "gold standard." PMID: 26924278
- knockdown of MED12 was shown to confer resistance to apoptosis following pediatric T-cell acute lymphoblastic leukemia relevant chemotherapy drug treatment in Jurkat leukemia cells PMID: 27602765
- Our findings provide new mechanistic insights into the MED12 functions and indicate that somatic nonsense mutations in early exons may avoid NMD. PMID: 28054750
- With a strong genotype-phenotype correlation that is already known for MED12, this could be a new phenotype linked to MED12, thus expanding the phenotypic spectrum of MED12-related disorders. PMID: 28544239
- The results suggest that MED12 mutations may contribute to chronic lymphocytic leukaemia pathogenesis by activating NOTCH signalling. PMID: 28771672
- we investigated several MED12 patients mutations (p.R206Q, p.N898D, p.R961W, p.N1007S, p.R1148H, p.S1165P and p.R1295H) and show that each MED12 mutations cause specific expression patterns of JUN, FOS and EGR1 immediate early genes (IEGs), reflected by the presence or absence of MED12 containing complex at their respective promoters. PMID: 28369444
- MED12 variants identified in males need to be evaluated carefully for these characteristics, as this severe phenotype may predict a potential risk for phenotypic expression in the heterozygotes. The identification of such a phenotype could influence the interpretation of future whole exome sequencing data and thus genetic counseling. PMID: 27312080
- Current study findings may help to narrow down the number of MED12 mutations to be screened for mediator complex dysfunction associated genetic diseases. This study supports computational methods as a primary filter to verify the plausible impact of pathogenic mutations based on the perspective of evolution, expression and phenotype of proteins. PMID: 26813965
- MED12-mutated adenosarcoma-like tumours might represent a distinct entity that requires more studies for its identification. MED12 exon 2 mutations seemed to have no significant role in other uncommon gynaecological mesenchymal tumours. PMID: 28002623
- role in the regulation of uterine fibroid cell proliferation through the modulation of Wnt/beta-catenin, cell cycle-associated, and fibrosis-associated protein expression PMID: 27967206
- Somatic MED12 mutations and biallelic FH inactivation are mutually exclusive in both HLRCC syndrome-associated and sporadic uterine leiomyomas. The great majority of HLRCC patients' uterine leiomyomas are caused by FH inactivation, but incidental tumours driven by somatic MED12 mutations also occur. PMID: 27187686
- 4.6% of leiomyosarcomas harbored MED12 exon 2 mutations, but the relevance of this association with molecular pathogenesis of leiomyosarcoma remains unknown. PMID: 27889101
- The high frequency and similar patterns of MED12 mutations in fibroadenomas and various grades of phyllodes tumours implies that the MED12 mutation is a common and early pathological event in these fibroepithelial tumours. PMID: 26109290
- Positive associations observed between MED12 and ERalpha, ERbeta immunohistochemical expression suggest a biological interplay between the proteins. PMID: 27056456
- increased MED12 exon 2 mutation frequency in the multiple Uterine Leiomyomas was not accompanied by significant alterations in the spectrum of mutation categories PMID: 26630226
- Patients with malignant PTs that harbored MED12 mutations demonstrated improved disease-free survival (DFS) compared with those without MED12 mutation PMID: 26856273
- MED12 mutations are associated with fibroid pathogenesis in a series of 103 uterine leiomyomas samples PMID: 26298726
- The biological function of MED12 and the relationship between MED12 mutations and diseases. Review. PMID: 23836153
- MED12 gene mutation is associated with Lujan-Fryns syndrome. PMID: 26358559
- Missense mutation in the MED12 gene is associated with hypertonia, eosinophilic esophagitis, penile chordee, and particular facial dysmorphisms beyond Ohdo syndrome. PMID: 26338144
- In conclusion, the authors demonstrated the restriction of MED12 exon 2 mutation to phyllodes tumours (73.6%, 39/53) and its absence in other spindle neoplasms of the breast. PMID: 26860948
- our results suggest that the majority of malignant breast phyllodes tumours may be driven by genetic/epigenetic alterations other than MED12 exon 2 somatic mutations PMID: 25855048
- Data suggest that MED13, MED12, CDK8 and cyclin C (CycC) comprise a four-subunit "kinase" module of the Mediator complex that functions as a major ingress of oncogenic and developmental signaling/gene expression in humans. [REVIEW] PMID: 26182352
- Frequent MED12 mutations in uterine leiomyosarcomas PMID: 26891131
- Specific somatic MED12 mutations in prostate cancer and uterine leiomyomas accumulate in two separate regions of the gene and promote tumorigenesis through clearly distinct mechanisms. PMID: 26383637
- This revealed four patients to have two or more tumors that were clonally related, all of which lacked MED12 mutations. DEPDC5 was discovered as a novel tumor suppressor gene playing a role in the progression of uterine leiomyomas. PMID: 25964426
- Frequent mutations in MED12 exon 2 in the phyllodes tumors suggest that it may share genetic etiology with uterine leiomyoma, a subgroup of uterine leiomyosarcomas and breast fibroadenoma. PMID: 25865354
- the MED12 mutation is implicated in the pathogenesis of both FA and PT and that a certain percentage of FAs with MED12 mutation may progress to PTs. PMID: 26093648
- MED12 mutations were closely associated with the development of uterine leiomyomas, as opposed to other uterine pathologies in Chinese patients, and PCR-based HRMA was found to be a reliable method for the detection of MED12 mutations. PMID: 25615570
- Results demonstrate frequent MED12 mutations in phyllodes tumors, supporting a shared origin with benign breast fibroadenomas. PMID: 25593300
- The results show frequent occurrence of MED12 mutations in fibroadenomas, intracanalicular fibroadenomas closely resemble benign phyllodes, benign phyllodes tumors harbor MED12 mutations, MED12 mutations in malignant phyllodes tumors are relatively rare. PMID: 25931199
- A critical role of TERT promoter mutations, in cooperation with MED12 mutations, in the development of phyllodes tumors. PMID: 26355235
- Additional studies on the role of MED12 mutation status as a putative prognostic factor as well as mutations' exact tumorigenic mechanism in CLL are warranted. PMID: 25595892
- Similar to fibroadenomas, breast phyllodes tumours show a high frequency of MED12 mutations, affirming the close biological relationship between these fibroepithelial neoplasms PMID: 26018969
- leiomyomatous, Med12 c.131G>A variant-expressing uteri developed chromosomal rearrangements. PMID: 26193636
- the relationship between MED12 mutations and uterine leiomyosarcoma and the lack of expression (by western blot or IHC) in most leiomyosarcoma is not correlated with mutational status. PMID: 26037152
- MED12 mutations were confined to the stromal components in both phyllodes tumours. PMID: 25839987
- Uterine leiomyoma (UL) pseudocapsules always showed a wild type MED12 gene status, even when associated with a UL harboring a specific MED12 aberration PMID: 25363374
- Mutational analysis of the MED12 gene revealed that leiomyomas exhibited mutations in the MED12 gene PMID: 25015674
- The MED12 gene exon 2 is frequently mutated in human uterine fibroids in Southern United States women. PMID: 25325994
- These results further emphasize the role of MED12 in uterine leiomyomas, show that exon 1 and exon 2 exert their tumorigenic effect in similar manner, and stress that exon 1 should be included in subsequent MED12 screenings. PMID: 24980722
顯示更多
收起更多
-
相關(guān)疾病:Opitz-Kaveggia syndrome (OKS); Lujan-Fryns syndrome (LUJFRYS); Ohdo syndrome, X-linked (OHDOX)
-
亞細(xì)胞定位:Nucleus.
-
蛋白家族:Mediator complex subunit 12 family
-
組織特異性:Ubiquitous.
-
數(shù)據(jù)庫鏈接:
Most popular with customers
-
-
YWHAB Recombinant Monoclonal Antibody
Applications: ELISA, WB, IHC, IF, FC
Species Reactivity: Human, Mouse, Rat
-
Phospho-YAP1 (S127) Recombinant Monoclonal Antibody
Applications: ELISA, WB, IHC
Species Reactivity: Human
-
-
-
-
-